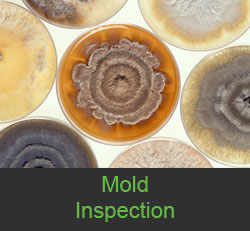
Image

Pre-Purchase Home Inspections
Potential home buyers utilize pre-purchase home inspections to provide an independent, unbiased evaluation of the condition of their prospective new home. During this process, major problems are disclosed so that they may be negotiated with the seller prior to purchasing the property. Having a full home inspection completed prior to purchasing a home is crucial to ensuring a sound, informed purchase.

Pre-Listing/Sale Inspections
Home sellers use pre-listing inspections as a tool to help ensure that the selling process goes as smoothly as possible. After the seller finds an interested and qualified buyer, the last thing they want is for unexpected and expensive repair items to show up on the buyer's home inspection report. By scheduling a pre-listing inspection, sellers can rest easier knowing that the chance of unwanted surprises appearing in a buyer's inspection report are significantly reduced.

Pre-Warranty Expiration Inspections
Sellers often include a warranty so buyers don’t have to worry about major home systems breaking shortly after closing. If you purchased a home with a warranty, it’s a great idea to have your home inspected before that warranty expires, so anything that is soon to break can be covered—potentially saving you a lot of money.
Mold Inspections
If you’re buying a new home or want to inspect your current property, it is important to look for mold. One effective way to do so is through a mold test. Because mold consists of spores that travel through the air, it can spread quickly. Additionally, mold creates mycotoxins, which are dangerous organisms that attack the immune system and jeopardize health.
IF YOU ARE IN THE NEED OF A CERTIFIED HOME INSPECTOR CONTACT
TDR INSPECTIONS TO SCHEDULE YOUR INSPECTION TODAY.
